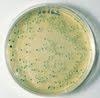
Métodos alternativos resultan eficaces para diagnosticar la tuberculosis Métodos alternativos resultan eficaces para diagnosticar la tuberculosis

PLoS Medicine recoge dos estudios sobre el diagnóstico de la tuberculosis, realizados por un equipo de investigadores dirigido por Luis E. Cuevas y Mohammed Yassin de la Escuela de Medicina Tropical de Liverpool, y coordinado conjuntamente con Andrew Ramsay del WHO-TDR Special Programme for Research and Training in Tropical Diseases. Los estudios tienen importantes implicaciones para la forma en que el diagnóstico de la enfermedad infecciosa endémica se puede realizar en países pobres.
Un estudio sugiere que no son necesarios tantos exámenes de esputo recogidos el mismo día en la consulta; y el otro que se podría llevar a cabo una prueba de laboratorio más rápida sin que esto afecte a la precisión del diagnóstico. Ambos estudios muestran que podrían utilizarse pruebas alternativas, eficaces y más convenientes para los pacientes en los países con menos recursos económicos
Los investigadores estudiaron el caso de 6.627 pacientes en Etiopía, Nepal, Nigeria y Yemen que habían tenido tos durante más de dos semanas un síntoma característico de la tuberculosis.
En el estudio principal los centros participantes fueron asignados al azar cada semana durante un año para utilizar diferentes métodos de recolección de esputo.Los resultados sugieren que un sistema de recogida de esputo en el que dos muestras se toman con una hora de diferencia añadiendo otra muestra recogida esa misma mañana podría resultar un diagnóstico igual de efectivo que el llamado 'spot-morning-spot' en el que los pacientes proporcionan una muestra durante su consulta inicial, una muestra recogida en su casa a la mañana siguiente, y otra más cuando llevan la muestra de la mañana a la clínica.
Según los autores, el diagnóstico podría no requerir más de una visita del paciente, el esquema de actuación que presentan tiene el potencial de mejorar el diagnóstico de la tuberculosis pulmonar en países de bajos y medianos ingresos. En el segundo estudio, que es un subestudio de la prueba principal, los investigadores examinaron a casi 2.400 pacientes para demostrar que una prueba de laboratorio más rápida, una variante de la bacterióscopica del frotis, podría identificar a más personas con tuberculosis que la prueba estándar.Los autores concluyen comentando que este estudio ha demostrado que la nueva prueba puede desempeñar un papel clave en la consecución de las metas de detección de la tuberculosis de la Organización Mundial de la Salud, la reducción de las cargas de trabajo de laboratorio, y asegurar el acceso de los pacientes pobres al diagnóstico y tratamiento oportuno.
**Publicado en "EL MEDICO INTERACTIVO"
